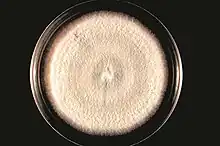

| Antibiotic | |
|---|---|
| Drug class | |
![]() Testing the susceptibility of Staphylococcus aureus to antibiotics by the Kirby-Bauer disk diffusion method – antibiotics diffuse from antibiotic-containing disks and inhibit growth of S. aureus, resulting in a zone of inhibition. | |
| Legal status | |
| In Wikidata |
An antibiotic is a type of antimicrobial substance active against bacteria. It is the most important type of antibacterial agent for fighting bacterial infections, and antibiotic medications are widely used in the treatment and prevention of such infections.[1][2] They may either kill or inhibit the growth of bacteria. A limited number of antibiotics also possess antiprotozoal activity.[3][4] Antibiotics are not effective against viruses such as the ones which cause the common cold or influenza;[5] drugs which inhibit growth of viruses are termed antiviral drugs or antivirals rather than antibiotics. They are also not effective against fungi; drugs which inhibit growth of fungi are called antifungal drugs.
Sometimes, the term antibiotic—literally "opposing life", from the Greek roots ἀντι anti, "against" and βίος bios, "life"—is broadly used to refer to any substance used against microbes, but in the usual medical usage, antibiotics (such as penicillin) are those produced naturally (by one microorganism fighting another), whereas non-antibiotic antibacterials (such as sulfonamides and antiseptics) are fully synthetic. However, both classes have the same goal of killing or preventing the growth of microorganisms, and both are included in antimicrobial chemotherapy. "Antibacterials" include bactericides, bacteriostatics, antibacterial soaps, and chemical disinfectants, whereas antibiotics are an important class of antibacterials used more specifically in medicine[6] and sometimes in livestock feed.
Antibiotics have been used since ancient times. Many civilizations used topical application of moldy bread, with many references to its beneficial effects arising from ancient Egypt, Nubia, China, Serbia, Greece, and Rome.[7] The first person to directly document the use of molds to treat infections was John Parkinson (1567–1650). Antibiotics revolutionized medicine in the 20th century. Alexander Fleming (1881–1955) discovered modern day penicillin in 1928, the widespread use of which proved significantly beneficial during wartime. However, the effectiveness and easy access to antibiotics have also led to their overuse[8] and some bacteria have evolved resistance to them.[1][9][10][11] The World Health Organization has classified antimicrobial resistance as a widespread "serious threat [that] is no longer a prediction for the future, it is happening right now in every region of the world and has the potential to affect anyone, of any age, in any country".[12] Global deaths attributable to antimicrobial resistance numbered 1.27 million in 2019.[13]
Etymology
The term 'antibiosis', meaning "against life", was introduced by the French bacteriologist Jean Paul Vuillemin as a descriptive name of the phenomenon exhibited by these early antibacterial drugs.[14][15][16] Antibiosis was first described in 1877 in bacteria when Louis Pasteur and Robert Koch observed that an airborne bacillus could inhibit the growth of Bacillus anthracis.[15][17] These drugs were later renamed antibiotics by Selman Waksman, an American microbiologist, in 1947.[18]
The term antibiotic was first used in 1942 by Selman Waksman and his collaborators in journal articles to describe any substance produced by a microorganism that is antagonistic to the growth of other microorganisms in high dilution.[15][19] This definition excluded substances that kill bacteria but that are not produced by microorganisms (such as gastric juices and hydrogen peroxide). It also excluded synthetic antibacterial compounds such as the sulfonamides. In current usage, the term "antibiotic" is applied to any medication that kills bacteria or inhibits their growth, regardless of whether that medication is produced by a microorganism or not.[20][21]
The term "antibiotic" derives from anti + βιωτικός (biōtikos), "fit for life, lively",[22] which comes from βίωσις (biōsis), "way of life",[23] and that from βίος (bios), "life".[24][25] The term "antibacterial" derives from Greek ἀντί (anti), "against"[26] + βακτήριον (baktērion), diminutive of βακτηρία (baktēria), "staff, cane",[27] because the first bacteria to be discovered were rod-shaped.[28]
Usage
Medical uses
Antibiotics are used to treat or prevent bacterial infections,[29] and sometimes protozoan infections. (Metronidazole is effective against a number of parasitic diseases). When an infection is suspected of being responsible for an illness but the responsible pathogen has not been identified, an empiric therapy is adopted.[30] This involves the administration of a broad-spectrum antibiotic based on the signs and symptoms presented and is initiated pending laboratory results that can take several days.[29][30]
When the responsible pathogenic microorganism is already known or has been identified, definitive therapy can be started. This will usually involve the use of a narrow-spectrum antibiotic. The choice of antibiotic given will also be based on its cost. Identification is critically important as it can reduce the cost and toxicity of the antibiotic therapy and also reduce the possibility of the emergence of antimicrobial resistance.[30] To avoid surgery, antibiotics may be given for non-complicated acute appendicitis.[31]
Antibiotics may be given as a preventive measure and this is usually limited to at-risk populations such as those with a weakened immune system (particularly in HIV cases to prevent pneumonia), those taking immunosuppressive drugs, cancer patients, and those having surgery.[29] Their use in surgical procedures is to help prevent infection of incisions. They have an important role in dental antibiotic prophylaxis where their use may prevent bacteremia and consequent infective endocarditis. Antibiotics are also used to prevent infection in cases of neutropenia particularly cancer-related.[32][33]
The use of antibiotics for secondary prevention of coronary heart disease is not supported by current scientific evidence, and may actually increase cardiovascular mortality, all-cause mortality and the occurrence of stroke.[34]
Routes of administration
There are many different routes of administration for antibiotic treatment. Antibiotics are usually taken by mouth. In more severe cases, particularly deep-seated systemic infections, antibiotics can be given intravenously or by injection.[1][30] Where the site of infection is easily accessed, antibiotics may be given topically in the form of eye drops onto the conjunctiva for conjunctivitis or ear drops for ear infections and acute cases of swimmer's ear. Topical use is also one of the treatment options for some skin conditions including acne and cellulitis.[35] Advantages of topical application include achieving high and sustained concentration of antibiotic at the site of infection; reducing the potential for systemic absorption and toxicity, and total volumes of antibiotic required are reduced, thereby also reducing the risk of antibiotic misuse.[36] Topical antibiotics applied over certain types of surgical wounds have been reported to reduce the risk of surgical site infections.[37] However, there are certain general causes for concern with topical administration of antibiotics. Some systemic absorption of the antibiotic may occur; the quantity of antibiotic applied is difficult to accurately dose, and there is also the possibility of local hypersensitivity reactions or contact dermatitis occurring.[36] It is recommended to administer antibiotics as soon as possible, especially in life-threatening infections. Many emergency departments stock antibiotics for this purpose.[38]
Global consumption
Antibiotic consumption varies widely between countries. The WHO report on surveillance of antibiotic consumption published in 2018 analysed 2015 data from 65 countries. As measured in defined daily doses per 1,000 inhabitants per day. Mongolia had the highest consumption with a rate of 64.4. Burundi had the lowest at 4.4. Amoxicillin and amoxicillin/clavulanic acid were the most frequently consumed.[39]
Side effects

Antibiotics are screened for any negative effects before their approval for clinical use, and are usually considered safe and well tolerated. However, some antibiotics have been associated with a wide extent of adverse side effects ranging from mild to very severe depending on the type of antibiotic used, the microbes targeted, and the individual patient.[40][41] Side effects may reflect the pharmacological or toxicological properties of the antibiotic or may involve hypersensitivity or allergic reactions.[4] Adverse effects range from fever and nausea to major allergic reactions, including photodermatitis and anaphylaxis.[42]
Common side effects of oral antibiotics include diarrhea, resulting from disruption of the species composition in the intestinal flora, resulting, for example, in overgrowth of pathogenic bacteria, such as Clostridium difficile.[43] Taking probiotics during the course of antibiotic treatment can help prevent antibiotic-associated diarrhea.[44] Antibacterials can also affect the vaginal flora, and may lead to overgrowth of yeast species of the genus Candida in the vulvo-vaginal area.[45] Additional side effects can result from interaction with other drugs, such as the possibility of tendon damage from the administration of a quinolone antibiotic with a systemic corticosteroid.[46]
Some antibiotics may also damage the mitochondrion, a bacteria-derived organelle found in eukaryotic, including human, cells. Mitochondrial damage cause oxidative stress in cells and has been suggested as a mechanism for side effects from fluoroquinolones.[47] They are also known to affect chloroplasts.[48]
Interactions
Birth control pills
There are few well-controlled studies on whether antibiotic use increases the risk of oral contraceptive failure.[49] The majority of studies indicate antibiotics do not interfere with birth control pills,[50] such as clinical studies that suggest the failure rate of contraceptive pills caused by antibiotics is very low (about 1%).[51] Situations that may increase the risk of oral contraceptive failure include non-compliance (missing taking the pill), vomiting, or diarrhea. Gastrointestinal disorders or interpatient variability in oral contraceptive absorption affecting ethinylestradiol serum levels in the blood.[49] Women with menstrual irregularities may be at higher risk of failure and should be advised to use backup contraception during antibiotic treatment and for one week after its completion. If patient-specific risk factors for reduced oral contraceptive efficacy are suspected, backup contraception is recommended.[49]
In cases where antibiotics have been suggested to affect the efficiency of birth control pills, such as for the broad-spectrum antibiotic rifampicin, these cases may be due to an increase in the activities of hepatic liver enzymes' causing increased breakdown of the pill's active ingredients.[50] Effects on the intestinal flora, which might result in reduced absorption of estrogens in the colon, have also been suggested, but such suggestions have been inconclusive and controversial.[52][53] Clinicians have recommended that extra contraceptive measures be applied during therapies using antibiotics that are suspected to interact with oral contraceptives.[50] More studies on the possible interactions between antibiotics and birth control pills (oral contraceptives) are required as well as careful assessment of patient-specific risk factors for potential oral contractive pill failure prior to dismissing the need for backup contraception.[49]
Alcohol
Interactions between alcohol and certain antibiotics may occur and may cause side effects and decreased effectiveness of antibiotic therapy.[54][55] While moderate alcohol consumption is unlikely to interfere with many common antibiotics, there are specific types of antibiotics with which alcohol consumption may cause serious side effects.[56] Therefore, potential risks of side effects and effectiveness depend on the type of antibiotic administered.[57]
Antibiotics such as metronidazole, tinidazole, cephamandole, latamoxef, cefoperazone, cefmenoxime, and furazolidone, cause a disulfiram-like chemical reaction with alcohol by inhibiting its breakdown by acetaldehyde dehydrogenase, which may result in vomiting, nausea, and shortness of breath.[56] In addition, the efficacy of doxycycline and erythromycin succinate may be reduced by alcohol consumption.[58] Other effects of alcohol on antibiotic activity include altered activity of the liver enzymes that break down the antibiotic compound.[24]
Pharmacodynamics
The successful outcome of antimicrobial therapy with antibacterial compounds depends on several factors. These include host defense mechanisms, the location of infection, and the pharmacokinetic and pharmacodynamic properties of the antibacterial.[59] The bactericidal activity of antibacterials may depend on the bacterial growth phase, and it often requires ongoing metabolic activity and division of bacterial cells.[60] These findings are based on laboratory studies, and in clinical settings have also been shown to eliminate bacterial infection.[59][61] Since the activity of antibacterials depends frequently on its concentration,[62] in vitro characterization of antibacterial activity commonly includes the determination of the minimum inhibitory concentration and minimum bactericidal concentration of an antibacterial.[59][63] To predict clinical outcome, the antimicrobial activity of an antibacterial is usually combined with its pharmacokinetic profile, and several pharmacological parameters are used as markers of drug efficacy.[64]
Combination therapy
In important infectious diseases, including tuberculosis, combination therapy (i.e., the concurrent application of two or more antibiotics) has been used to delay or prevent the emergence of resistance. In acute bacterial infections, antibiotics as part of combination therapy are prescribed for their synergistic effects to improve treatment outcome as the combined effect of both antibiotics is better than their individual effect.[65][66] Fosfomycin has the highest number of synergistic combinations among antibiotics and is almost always used as a partner drug.[67] Methicillin-resistant Staphylococcus aureus infections may be treated with a combination therapy of fusidic acid and rifampicin.[65] Antibiotics used in combination may also be antagonistic and the combined effects of the two antibiotics may be less than if one of the antibiotics was given as a monotherapy.[65] For example, chloramphenicol and tetracyclines are antagonists to penicillins. However, this can vary depending on the species of bacteria.[68] In general, combinations of a bacteriostatic antibiotic and bactericidal antibiotic are antagonistic.[65][66]
In addition to combining one antibiotic with another, antibiotics are sometimes co-administered with resistance-modifying agents. For example, β-lactam antibiotics may be used in combination with β-lactamase inhibitors, such as clavulanic acid or sulbactam, when a patient is infected with a β-lactamase-producing strain of bacteria.[69]
Classes
Molecular targets of antibiotics on the bacteria cell
Protein synthesis inhibitors (antibiotics)
Antibiotics are commonly classified based on their mechanism of action, chemical structure, or spectrum of activity. Most target bacterial functions or growth processes.[14] Those that target the bacterial cell wall (penicillins and cephalosporins) or the cell membrane (polymyxins), or interfere with essential bacterial enzymes (rifamycins, lipiarmycins, quinolones, and sulfonamides) have bactericidal activities, killing the bacteria. Protein synthesis inhibitors (macrolides, lincosamides, and tetracyclines) are usually bacteriostatic, inhibiting further growth (with the exception of bactericidal aminoglycosides).[70] Further categorization is based on their target specificity. "Narrow-spectrum" antibiotics target specific types of bacteria, such as gram-negative or gram-positive, whereas broad-spectrum antibiotics affect a wide range of bacteria. Following a 40-year break in discovering classes of antibacterial compounds, four new classes of antibiotics were introduced to clinical use in the late 2000s and early 2010s: cyclic lipopeptides (such as daptomycin), glycylcyclines (such as tigecycline), oxazolidinones (such as linezolid), and lipiarmycins (such as fidaxomicin).[71][72]
Production
With advances in medicinal chemistry, most modern antibacterials are semisynthetic modifications of various natural compounds.[73] These include, for example, the beta-lactam antibiotics, which include the penicillins (produced by fungi in the genus Penicillium), the cephalosporins, and the carbapenems. Compounds that are still isolated from living organisms are the aminoglycosides, whereas other antibacterials—for example, the sulfonamides, the quinolones, and the oxazolidinones—are produced solely by chemical synthesis.[73] Many antibacterial compounds are relatively small molecules with a molecular weight of less than 1000 daltons.[74]
Since the first pioneering efforts of Howard Florey and Chain in 1939, the importance of antibiotics, including antibacterials, to medicine has led to intense research into producing antibacterials at large scales. Following screening of antibacterials against a wide range of bacteria, production of the active compounds is carried out using fermentation, usually in strongly aerobic conditions.[75]
Resistance

The emergence of antibiotic-resistant bacteria is a common phenomenon mainly caused by the overuse/misuse. It represents a threat to health globally.[76]
Emergence of resistance often reflects evolutionary processes that take place during antibiotic therapy. The antibiotic treatment may select for bacterial strains with physiologically or genetically enhanced capacity to survive high doses of antibiotics. Under certain conditions, it may result in preferential growth of resistant bacteria, while growth of susceptible bacteria is inhibited by the drug.[77] For example, antibacterial selection for strains having previously acquired antibacterial-resistance genes was demonstrated in 1943 by the Luria–Delbrück experiment.[78] Antibiotics such as penicillin and erythromycin, which used to have a high efficacy against many bacterial species and strains, have become less effective, due to the increased resistance of many bacterial strains.[79]
Resistance may take the form of biodegradation of pharmaceuticals, such as sulfamethazine-degrading soil bacteria introduced to sulfamethazine through medicated pig feces.[80] The survival of bacteria often results from an inheritable resistance,[81] but the growth of resistance to antibacterials also occurs through horizontal gene transfer. Horizontal transfer is more likely to happen in locations of frequent antibiotic use.[82]
Antibacterial resistance may impose a biological cost, thereby reducing fitness of resistant strains, which can limit the spread of antibacterial-resistant bacteria, for example, in the absence of antibacterial compounds. Additional mutations, however, may compensate for this fitness cost and can aid the survival of these bacteria.[83]
Paleontological data show that both antibiotics and antibiotic resistance are ancient compounds and mechanisms.[84] Useful antibiotic targets are those for which mutations negatively impact bacterial reproduction or viability.[85]
Several molecular mechanisms of antibacterial resistance exist. Intrinsic antibacterial resistance may be part of the genetic makeup of bacterial strains.[86][87] For example, an antibiotic target may be absent from the bacterial genome. Acquired resistance results from a mutation in the bacterial chromosome or the acquisition of extra-chromosomal DNA.[86] Antibacterial-producing bacteria have evolved resistance mechanisms that have been shown to be similar to, and may have been transferred to, antibacterial-resistant strains.[88][89] The spread of antibacterial resistance often occurs through vertical transmission of mutations during growth and by genetic recombination of DNA by horizontal genetic exchange.[81] For instance, antibacterial resistance genes can be exchanged between different bacterial strains or species via plasmids that carry these resistance genes.[81][90] Plasmids that carry several different resistance genes can confer resistance to multiple antibacterials.[90] Cross-resistance to several antibacterials may also occur when a resistance mechanism encoded by a single gene conveys resistance to more than one antibacterial compound.[90]
Antibacterial-resistant strains and species, sometimes referred to as "superbugs", now contribute to the emergence of diseases that were, for a while, well controlled. For example, emergent bacterial strains causing tuberculosis that are resistant to previously effective antibacterial treatments pose many therapeutic challenges. Every year, nearly half a million new cases of multidrug-resistant tuberculosis (MDR-TB) are estimated to occur worldwide.[91] For example, NDM-1 is a newly identified enzyme conveying bacterial resistance to a broad range of beta-lactam antibacterials.[92] The United Kingdom's Health Protection Agency has stated that "most isolates with NDM-1 enzyme are resistant to all standard intravenous antibiotics for treatment of severe infections."[93] On 26 May 2016, an E. coli "superbug" was identified in the United States resistant to colistin, "the last line of defence" antibiotic.[94][95] In recent years, even anaerobic bacteria, historically considered less concerning in terms of resistance, have demonstrated high rates of antibiotic resistance, particularly Bacteroides, for which resistance rates to penicillin have been reported to exceed 90%.[96]
Misuse

Per The ICU Book "The first rule of antibiotics is to try not to use them, and the second rule is try not to use too many of them."[97] Inappropriate antibiotic treatment and overuse of antibiotics have contributed to the emergence of antibiotic-resistant bacteria. However, potential harm from antibiotics extends beyond selection of antimicrobial resistance and their overuse is associated with adverse effects for patients themselves, seen most clearly in critically ill patients in Intensive care units.[98] Self-prescribing of antibiotics is an example of misuse.[99] Many antibiotics are frequently prescribed to treat symptoms or diseases that do not respond to antibiotics or that are likely to resolve without treatment. Also, incorrect or suboptimal antibiotics are prescribed for certain bacterial infections.[40][99] The overuse of antibiotics, like penicillin and erythromycin, has been associated with emerging antibiotic resistance since the 1950s.[79][100] Widespread usage of antibiotics in hospitals has also been associated with increases in bacterial strains and species that no longer respond to treatment with the most common antibiotics.[100]
Common forms of antibiotic misuse include excessive use of prophylactic antibiotics in travelers and failure of medical professionals to prescribe the correct dosage of antibiotics on the basis of the patient's weight and history of prior use. Other forms of misuse include failure to take the entire prescribed course of the antibiotic, incorrect dosage and administration, or failure to rest for sufficient recovery. Inappropriate antibiotic treatment, for example, is their prescription to treat viral infections such as the common cold. One study on respiratory tract infections found "physicians were more likely to prescribe antibiotics to patients who appeared to expect them".[101] Multifactorial interventions aimed at both physicians and patients can reduce inappropriate prescription of antibiotics.[102][103] The lack of rapid point of care diagnostic tests, particularly in resource-limited settings is considered one of the drivers of antibiotic misuse.[104]
Several organizations concerned with antimicrobial resistance are lobbying to eliminate the unnecessary use of antibiotics.[99] The issues of misuse and overuse of antibiotics have been addressed by the formation of the US Interagency Task Force on Antimicrobial Resistance. This task force aims to actively address antimicrobial resistance, and is coordinated by the US Centers for Disease Control and Prevention, the Food and Drug Administration (FDA), and the National Institutes of Health, as well as other US agencies.[105] A non-governmental organization campaign group is Keep Antibiotics Working.[106] In France, an "Antibiotics are not automatic" government campaign started in 2002 and led to a marked reduction of unnecessary antibiotic prescriptions, especially in children.[107]
The emergence of antibiotic resistance has prompted restrictions on their use in the UK in 1970 (Swann report 1969), and the European Union has banned the use of antibiotics as growth-promotional agents since 2003.[108] Moreover, several organizations (including the World Health Organization, the National Academy of Sciences, and the U.S. Food and Drug Administration) have advocated restricting the amount of antibiotic use in food animal production.[109] However, commonly there are delays in regulatory and legislative actions to limit the use of antibiotics, attributable partly to resistance against such regulation by industries using or selling antibiotics, and to the time required for research to test causal links between their use and resistance to them. Two federal bills (S.742[110] and H.R. 2562[111]) aimed at phasing out nontherapeutic use of antibiotics in US food animals were proposed, but have not passed.[110][111] These bills were endorsed by public health and medical organizations, including the American Holistic Nurses' Association, the American Medical Association, and the American Public Health Association.[112][113]
Despite pledges by food companies and restaurants to reduce or eliminate meat that comes from animals treated with antibiotics, the purchase of antibiotics for use on farm animals has been increasing every year.[114]
There has been extensive use of antibiotics in animal husbandry. In the United States, the question of emergence of antibiotic-resistant bacterial strains due to use of antibiotics in livestock was raised by the US Food and Drug Administration (FDA) in 1977. In March 2012, the United States District Court for the Southern District of New York, ruling in an action brought by the Natural Resources Defense Council and others, ordered the FDA to revoke approvals for the use of antibiotics in livestock, which violated FDA regulations.[115]
Studies have shown that common misconceptions about the effectiveness and necessity of antibiotics to treat common mild illnesses contribute to their overuse.[116][117]
Other forms of antibiotic associated harm include anaphylaxis, drug toxicity most notably kidney and liver damage, and super-infections with resistant organisms. Antibiotics are also known to affect mitochondrial function,[118] and this may contribute to the bioenergetic failure of immune cells seen in sepsis.[119] They also alter the microbiome of the gut, lungs and skin,[120] which may be associated with adverse effects such as Clostridium difficile associated diarrhoea. Whilst antibiotics can clearly be lifesaving in patients with bacterial infections, their overuse, especially in patients where infections are hard to diagnose, can lead to harm via multiple mechanisms.[98]
History
Before the early 20th century, treatments for infections were based primarily on medicinal folklore. Mixtures with antimicrobial properties that were used in treatments of infections were described over 2,000 years ago.[121] Many ancient cultures, including the ancient Egyptians and ancient Greeks, used specially selected mold and plant materials to treat infections.[122][123] Nubian mummies studied in the 1990s were found to contain significant levels of tetracycline. The beer brewed at that time was conjectured to have been the source.[124]
The use of antibiotics in modern medicine began with the discovery of synthetic antibiotics derived from dyes.[14][125][126][127][128]Various Essential oils have been shown to have anti-microbial properties.[129] Along with this, the plants from which these oils have been derived from can be used as niche anti-microbial agents.[130]
Synthetic antibiotics derived from dyes

Synthetic antibiotic chemotherapy as a science and development of antibacterials began in Germany with Paul Ehrlich in the late 1880s.[14] Ehrlich noted certain dyes would colour human, animal, or bacterial cells, whereas others did not. He then proposed the idea that it might be possible to create chemicals that would act as a selective drug that would bind to and kill bacteria without harming the human host. After screening hundreds of dyes against various organisms, in 1907, he discovered a medicinally useful drug, the first synthetic antibacterial organoarsenic compound salvarsan,[14][125][126] now called arsphenamine.
This heralded the era of antibacterial treatment that was begun with the discovery of a series of arsenic-derived synthetic antibiotics by both Alfred Bertheim and Ehrlich in 1907.[127][128] Ehrlich and Bertheim had experimented with various chemicals derived from dyes to treat trypanosomiasis in mice and spirochaeta infection in rabbits. While their early compounds were too toxic, Ehrlich and Sahachiro Hata, a Japanese bacteriologist working with Erlich in the quest for a drug to treat syphilis, achieved success with the 606th compound in their series of experiments. In 1910, Ehrlich and Hata announced their discovery, which they called drug "606", at the Congress for Internal Medicine at Wiesbaden.[131] The Hoechst company began to market the compound toward the end of 1910 under the name Salvarsan, now known as arsphenamine.[131] The drug was used to treat syphilis in the first half of the 20th century. In 1908, Ehrlich received the Nobel Prize in Physiology or Medicine for his contributions to immunology.[132] Hata was nominated for the Nobel Prize in Chemistry in 1911 and for the Nobel Prize in Physiology or Medicine in 1912 and 1913.[133]
The first sulfonamide and the first systemically active antibacterial drug, Prontosil, was developed by a research team led by Gerhard Domagk in 1932 or 1933 at the Bayer Laboratories of the IG Farben conglomerate in Germany,[128][134][126] for which Domagk received the 1939 Nobel Prize in Physiology or Medicine.[135] Sulfanilamide, the active drug of Prontosil, was not patentable as it had already been in use in the dye industry for some years.[134] Prontosil had a relatively broad effect against Gram-positive cocci, but not against enterobacteria. Research was stimulated apace by its success. The discovery and development of this sulfonamide drug opened the era of antibacterials.[136][137]
Penicillin and other natural antibiotics

Observations about the growth of some microorganisms inhibiting the growth of other microorganisms have been reported since the late 19th century. These observations of antibiosis between microorganisms led to the discovery of natural antibacterials. Louis Pasteur observed, "if we could intervene in the antagonism observed between some bacteria, it would offer perhaps the greatest hopes for therapeutics".[138]
In 1874, physician Sir William Roberts noted that cultures of the mould Penicillium glaucum that is used in the making of some types of blue cheese did not display bacterial contamination.[139]
In 1895 Vincenzo Tiberio, Italian physician, published a paper on the antibacterial power of some extracts of mold.[140]
In 1897, doctoral student Ernest Duchesne submitted a dissertation, "Contribution à l'étude de la concurrence vitale chez les micro-organismes: antagonisme entre les moisissures et les microbes" (Contribution to the study of vital competition in micro-organisms: antagonism between moulds and microbes),[141] the first known scholarly work to consider the therapeutic capabilities of moulds resulting from their anti-microbial activity. In his thesis, Duchesne proposed that bacteria and moulds engage in a perpetual battle for survival. Duchesne observed that E. coli was eliminated by Penicillium glaucum when they were both grown in the same culture. He also observed that when he inoculated laboratory animals with lethal doses of typhoid bacilli together with Penicillium glaucum, the animals did not contract typhoid. Duchesne's army service after getting his degree prevented him from doing any further research.[142] Duchesne died of tuberculosis, a disease now treated by antibiotics.[142]
In 1928, Sir Alexander Fleming postulated the existence of penicillin, a molecule produced by certain moulds that kills or stops the growth of certain kinds of bacteria. Fleming was working on a culture of disease-causing bacteria when he noticed the spores of a green mold, Penicillium rubens,[143] in one of his culture plates. He observed that the presence of the mould killed or prevented the growth of the bacteria.[144] Fleming postulated that the mould must secrete an antibacterial substance, which he named penicillin in 1928. Fleming believed that its antibacterial properties could be exploited for chemotherapy. He initially characterised some of its biological properties, and attempted to use a crude preparation to treat some infections, but he was unable to pursue its further development without the aid of trained chemists.[145][146]
Ernst Chain, Howard Florey and Edward Abraham succeeded in purifying the first penicillin, penicillin G, in 1942, but it did not become widely available outside the Allied military before 1945. Later, Norman Heatley developed the back extraction technique for efficiently purifying penicillin in bulk. The chemical structure of penicillin was first proposed by Abraham in 1942[147] and then later confirmed by Dorothy Crowfoot Hodgkin in 1945. Purified penicillin displayed potent antibacterial activity against a wide range of bacteria and had low toxicity in humans. Furthermore, its activity was not inhibited by biological constituents such as pus, unlike the synthetic sulfonamides. (see below) The development of penicillin led to renewed interest in the search for antibiotic compounds with similar efficacy and safety.[148] For their successful development of penicillin, which Fleming had accidentally discovered but could not develop himself, as a therapeutic drug, Chain and Florey shared the 1945 Nobel Prize in Medicine with Fleming.[149]
Florey credited René Dubos with pioneering the approach of deliberately and systematically searching for antibacterial compounds, which had led to the discovery of gramicidin and had revived Florey's research in penicillin.[150] In 1939, coinciding with the start of World War II, Dubos had reported the discovery of the first naturally derived antibiotic, tyrothricin, a compound of 20% gramicidin and 80% tyrocidine, from Bacillus brevis. It was one of the first commercially manufactured antibiotics and was very effective in treating wounds and ulcers during World War II.[150] Gramicidin, however, could not be used systemically because of toxicity. Tyrocidine also proved too toxic for systemic usage. Research results obtained during that period were not shared between the Axis and the Allied powers during World War II and limited access during the Cold War.[151]
Late 20th century
During the mid-20th century, the number of new antibiotic substances introduced for medical use increased significantly. From 1935 to 1968, 12 new classes were launched. However, after this, the number of new classes dropped markedly, with only two new classes introduced between 1969 and 2003.[152]
Antibiotic pipeline
Both the WHO and the Infectious Disease Society of America report that the weak antibiotic pipeline does not match bacteria's increasing ability to develop resistance.[153][154] The Infectious Disease Society of America report noted that the number of new antibiotics approved for marketing per year had been declining and identified seven antibiotics against the Gram-negative bacilli currently in phase 2 or phase 3 clinical trials. However, these drugs did not address the entire spectrum of resistance of Gram-negative bacilli.[155][156] According to the WHO fifty one new therapeutic entities - antibiotics (including combinations), are in phase 1-3 clinical trials as of May 2017.[153] Antibiotics targeting multidrug-resistant Gram-positive pathogens remains a high priority.[157][153]
A few antibiotics have received marketing authorization in the last seven years. The cephalosporin ceftaroline and the lipoglycopeptides oritavancin and telavancin have been approved for the treatment of acute bacterial skin and skin structure infection and community-acquired bacterial pneumonia.[158] The lipoglycopeptide dalbavancin and the oxazolidinone tedizolid has also been approved for use for the treatment of acute bacterial skin and skin structure infection. The first in a new class of narrow spectrum macrocyclic antibiotics, fidaxomicin, has been approved for the treatment of C. difficile colitis.[158] New cephalosporin-lactamase inhibitor combinations also approved include ceftazidime-avibactam and ceftolozane-avibactam for complicated urinary tract infection and intra-abdominal infection.[158]
- Ceftolozane/tazobactam (CXA-201; CXA-101/tazobactam): Antipseudomonal cephalosporin/β-lactamase inhibitor combination (cell wall synthesis inhibitor). FDA approved on 19 December 2014.
- Ceftazidime/avibactam (ceftazidime/NXL104): antipseudomonal cephalosporin/β-lactamase inhibitor combination (cell wall synthesis inhibitor).[159] FDA approved on 25 February 2015.
- Ceftaroline/avibactam (CPT-avibactam; ceftaroline/NXL104): Anti-MRSA cephalosporin/ β-lactamase inhibitor combination (cell wall synthesis inhibitor).
- Cefiderocol: cephalosporin siderophore.[159] FDA approved on 14 November 2019.
- Imipenem/relebactam: carbapenem/ β-lactamase inhibitor combination (cell wall synthesis inhibitor).[159] FDA approved on 16 July 2019.
- Meropenem/vaborbactam: carbapenem/ β-lactamase inhibitor combination (cell wall synthesis inhibitor).[159] FDA approved on 29 August 2017.
- Delafloxacin: quinolone (inhibitor of DNA synthesis).[159] FDA approved on 19 June 2017.
- Plazomicin (ACHN-490): semi-synthetic aminoglycoside derivative (protein synthesis inhibitor).[159] FDA approved 25 June 2018.
- Eravacycline (TP-434): synthetic tetracycline derivative (protein synthesis inhibitor targeting bacterial ribosomes).[159] FDA approved on 27 August 2018.
- Omadacycline: semi-synthetic tetracycline derivative (protein synthesis inhibitor targeting bacterial ribosomes).[159] FDA approved on 2 October 2018.
- Lefamulin: pleuromutilin antibiotic.[159] FDA approved on 19 August 2019.
- Brilacidin (PMX-30063): peptide defense protein mimetic (cell membrane disruption). In phase 2.
- Zosurabalpin (RG-6006): lipopolysaccharide transport inhibitor. In phase 1.[160][161]
Possible improvements include clarification of clinical trial regulations by FDA. Furthermore, appropriate economic incentives could persuade pharmaceutical companies to invest in this endeavor.[156] In the US, the Antibiotic Development to Advance Patient Treatment (ADAPT) Act was introduced with the aim of fast tracking the drug development of antibiotics to combat the growing threat of 'superbugs'. Under this Act, FDA can approve antibiotics and antifungals treating life-threatening infections based on smaller clinical trials. The CDC will monitor the use of antibiotics and the emerging resistance, and publish the data. The FDA antibiotics labeling process, 'Susceptibility Test Interpretive Criteria for Microbial Organisms' or 'breakpoints', will provide accurate data to healthcare professionals.[162] According to Allan Coukell, senior director for health programs at The Pew Charitable Trusts, "By allowing drug developers to rely on smaller datasets, and clarifying FDA's authority to tolerate a higher level of uncertainty for these drugs when making a risk/benefit calculation, ADAPT would make the clinical trials more feasible."[163]
Replenishing the antibiotic pipeline and developing other new therapies
Because antibiotic-resistant bacterial strains continue to emerge and spread, there is a constant need to develop new antibacterial treatments. Current strategies include traditional chemistry-based approaches such as natural product-based drug discovery,[164][165] newer chemistry-based approaches such as drug design,[166][167] traditional biology-based approaches such as immunoglobulin therapy,[168][169] and experimental biology-based approaches such as phage therapy,[170][171] fecal microbiota transplants,[168][172] antisense RNA-based treatments,[168][169] and CRISPR-Cas9-based treatments.[168][169][173]
Natural product-based antibiotic discovery
Most of the antibiotics in current use are natural products or natural product derivatives,[165][174] and bacterial,[175][176] fungal,[164][177] plant[178][179][180][181] and animal[164][182] extracts are being screened in the search for new antibiotics. Organisms may be selected for testing based on ecological, ethnomedical, genomic, or historical rationales.[165] Medicinal plants, for example, are screened on the basis that they are used by traditional healers to prevent or cure infection and may therefore contain antibacterial compounds.[183][184] Also, soil bacteria are screened on the basis that, historically, they have been a very rich source of antibiotics (with 70 to 80% of antibiotics in current use derived from the actinomycetes).[165][185]
In addition to screening natural products for direct antibacterial activity, they are sometimes screened for the ability to suppress antibiotic resistance and antibiotic tolerance.[184][186] For example, some secondary metabolites inhibit drug efflux pumps, thereby increasing the concentration of antibiotic able to reach its cellular target and decreasing bacterial resistance to the antibiotic.[184][187] Natural products known to inhibit bacterial efflux pumps include the alkaloid lysergol,[188] the carotenoids capsanthin and capsorubin,[189] and the flavonoids rotenone and chrysin.[189] Other natural products, this time primary metabolites rather than secondary metabolites, have been shown to eradicate antibiotic tolerance. For example, glucose, mannitol, and fructose reduce antibiotic tolerance in Escherichia coli and Staphylococcus aureus, rendering them more susceptible to killing by aminoglycoside antibiotics.[186]
Natural products may be screened for the ability to suppress bacterial virulence factors too. Virulence factors are molecules, cellular structures and regulatory systems that enable bacteria to evade the body's immune defenses (e.g. urease, staphyloxanthin), move towards, attach to, and/or invade human cells (e.g. type IV pili, adhesins, internalins), coordinate the activation of virulence genes (e.g. quorum sensing), and cause disease (e.g. exotoxins).[168][181][190][191][192] Examples of natural products with antivirulence activity include the flavonoid epigallocatechin gallate (which inhibits listeriolysin O),[190] the quinone tetrangomycin (which inhibits staphyloxanthin),[191] and the sesquiterpene zerumbone (which inhibits Acinetobacter baumannii motility).[193]
Immunoglobulin therapy
Antibodies (anti-tetanus immunoglobulin) have been used in the treatment and prevention of tetanus since the 1910s,[194] and this approach continues to be a useful way of controlling bacterial diseases. The monoclonal antibody bezlotoxumab, for example, has been approved by the US FDA and EMA for recurrent Clostridium difficile infection, and other monoclonal antibodies are in development (e.g. AR-301 for the adjunctive treatment of S. aureus ventilator-associated pneumonia). Antibody treatments act by binding to and neutralizing bacterial exotoxins and other virulence factors.[168][169]
Phage therapy

Phage therapy is under investigation as a method of treating antibiotic-resistant strains of bacteria. Phage therapy involves infecting bacterial pathogens with viruses. Bacteriophages and their host ranges are extremely specific for certain bacteria, thus, unlike antibiotics, they do not disturb the host organism's intestinal microbiota.[196] Bacteriophages, also known as phages, infect and kill bacteria primarily during lytic cycles.[196][195] Phages insert their DNA into the bacterium, where it is transcribed and used to make new phages, after which the cell will lyse, releasing new phage that are able to infect and destroy further bacteria of the same strain.[195] The high specificity of phage protects "good" bacteria from destruction.[197]
Some disadvantages to the use of bacteriophages also exist, however. Bacteriophages may harbour virulence factors or toxic genes in their genomes and, prior to use, it may be prudent to identify genes with similarity to known virulence factors or toxins by genomic sequencing. In addition, the oral and IV administration of phages for the eradication of bacterial infections poses a much higher safety risk than topical application. Also, there is the additional concern of uncertain immune responses to these large antigenic cocktails.
There are considerable regulatory hurdles that must be cleared for such therapies.[196] Despite numerous challenges, the use of bacteriophages as a replacement for antimicrobial agents against MDR pathogens that no longer respond to conventional antibiotics, remains an attractive option.[196][198]
Fecal microbiota transplants

Fecal microbiota transplants involve transferring the full intestinal microbiota from a healthy human donor (in the form of stool) to patients with C. difficile infection. Although this procedure has not been officially approved by the US FDA, its use is permitted under some conditions in patients with antibiotic-resistant C. difficile infection. Cure rates are around 90%, and work is underway to develop stool banks, standardized products, and methods of oral delivery.[168] Fecal microbiota transplantation has also been used more recently for inflammatory bowel diseases.[199]
Antisense RNA-based treatments
Antisense RNA-based treatment (also known as gene silencing therapy) involves (a) identifying bacterial genes that encode essential proteins (e.g. the Pseudomonas aeruginosa genes acpP, lpxC, and rpsJ), (b) synthesizing single stranded RNA that is complementary to the mRNA encoding these essential proteins, and (c) delivering the single stranded RNA to the infection site using cell-penetrating peptides or liposomes. The antisense RNA then hybridizes with the bacterial mRNA and blocks its translation into the essential protein. Antisense RNA-based treatment has been shown to be effective in in vivo models of P. aeruginosa pneumonia.[168][169]
In addition to silencing essential bacterial genes, antisense RNA can be used to silence bacterial genes responsible for antibiotic resistance.[168][169] For example, antisense RNA has been developed that silences the S. aureus mecA gene (the gene that encodes modified penicillin-binding protein 2a and renders S. aureus strains methicillin-resistant). Antisense RNA targeting mecA mRNA has been shown to restore the susceptibility of methicillin-resistant staphylococci to oxacillin in both in vitro and in vivo studies.[169]
CRISPR-Cas9-based treatments
In the early 2000s, a system was discovered that enables bacteria to defend themselves against invading viruses. The system, known as CRISPR-Cas9, consists of (a) an enzyme that destroys DNA (the nuclease Cas9) and (b) the DNA sequences of previously encountered viral invaders (CRISPR). These viral DNA sequences enable the nuclease to target foreign (viral) rather than self (bacterial) DNA.[200]
Although the function of CRISPR-Cas9 in nature is to protect bacteria, the DNA sequences in the CRISPR component of the system can be modified so that the Cas9 nuclease targets bacterial resistance genes or bacterial virulence genes instead of viral genes. The modified CRISPR-Cas9 system can then be administered to bacterial pathogens using plasmids or bacteriophages.[168][169] This approach has successfully been used to silence antibiotic resistance and reduce the virulence of enterohemorrhagic E. coli in an in vivo model of infection.[169]
Reducing the selection pressure for antibiotic resistance

In addition to developing new antibacterial treatments, it is important to reduce the selection pressure for the emergence and spread of antibiotic resistance. Strategies to accomplish this include well-established infection control measures such as infrastructure improvement (e.g. less crowded housing),[202][203] better sanitation (e.g. safe drinking water and food)[204][205] and vaccine development,[171] other approaches such as antibiotic stewardship,[206][207] and experimental approaches such as the use of prebiotics and probiotics to prevent infection.[208][209][210][211] Antibiotic cycling, where antibiotics are alternated by clinicians to treat microbial diseases, is proposed, but recent studies revealed such strategies are ineffective against antibiotic resistance.[212][213]
Vaccines
Vaccines rely on immune modulation or augmentation. Vaccination either excites or reinforces the immune competence of a host to ward off infection, leading to the activation of macrophages, the production of antibodies, inflammation, and other classic immune reactions. Antibacterial vaccines have been responsible for a drastic reduction in global bacterial diseases.[214] Vaccines made from attenuated whole cells or lysates have been replaced largely by less reactogenic, cell-free vaccines consisting of purified components, including capsular polysaccharides and their conjugates, to protein carriers, as well as inactivated toxins (toxoids) and proteins.[215]
See also
References
- 1 2 3 "Antibiotics". NHS. 5 June 2014. Archived from the original on 18 January 2015. Retrieved 17 January 2015.
- ↑ "Factsheet for experts". European Centre for Disease Prevention and Control. Archived from the original on 21 December 2014. Retrieved 21 December 2014.
- ↑ For example, metronidazole: "Metronidazole". The American Society of Health-System Pharmacists. Archived from the original on 6 September 2015. Retrieved 31 July 2015.
- 1 2 Chemical Analysis of Antibiotic Residues in Food. John Wiley & Sons, Inc. 2012. pp. 1–60. ISBN 978-1-4496-1459-1.
- ↑ "Why antibiotics can't be used to treat your cold or flu". www.health.qld.gov.au. 6 May 2017. Archived from the original on 9 August 2020. Retrieved 13 May 2020.
- ↑ "General Background: Antibiotic Agents". Alliance for the Prudent Use of Antibiotics. Archived from the original on 14 December 2014. Retrieved 21 December 2014.
- ↑ Gould K (March 2016). "Antibiotics: from prehistory to the present day". Journal of Antimicrobial Chemotherapy. 71 (3): 572–575. doi:10.1093/jac/dkv484. ISSN 0305-7453. PMID 26851273.
- ↑ Laxminarayan R, Duse A, Wattal C, Zaidi AK, Wertheim HF, Sumpradit N, et al. (December 2013). "Antibiotic resistance-the need for global solutions". The Lancet. Infectious Diseases. 13 (12): 1057–98. doi:10.1016/S1473-3099(13)70318-9. hdl:10161/8996. PMID 24252483. S2CID 19489131. Archived from the original on 10 June 2020. Retrieved 25 August 2020.
- ↑ Brooks M (16 November 2015). "Public Confused About Antibiotic Resistance, WHO Says". Medscape Multispeciality. Archived from the original on 20 November 2015. Retrieved 21 November 2015.
- ↑ Gould K (March 2016). "Antibiotics: from prehistory to the present day". The Journal of Antimicrobial Chemotherapy. 71 (3): 572–5. doi:10.1093/jac/dkv484. PMID 26851273.
- ↑ Gualerzi CO, Brandi L, Fabbretti A, Pon CL (4 December 2013). Antibiotics: Targets, Mechanisms and Resistance. John Wiley & Sons. p. 1. ISBN 978-3-527-33305-9.
- ↑ Antimicrobial resistance: global report on surveillance (PDF). The World Health Organization. April 2014. ISBN 978-92-4-156474-8. Archived (PDF) from the original on 6 June 2016. Retrieved 13 June 2016.
- ↑ Murray CJ, Ikuta KS, Sharara F, Swetschinski L, Robles Aguilar G, Gray A, et al. (February 2022). "Global burden of bacterial antimicrobial resistance in 2019: a systematic analysis". Lancet. 399 (10325): 629–655. doi:10.1016/S0140-6736(21)02724-0. PMC 8841637. PMID 35065702.
- 1 2 3 4 5 Calderon CB, Sabundayo BP (2007). Antimicrobial Classifications: Drugs for Bugs. In Schwalbe R, Steele-Moore L, Goodwin AC. Antimicrobial Susceptibility Testing Protocols. CRC Press. Taylor & Frances group. ISBN 978-0-8247-4100-6
- 1 2 3 Saxena S (2015). "Chapter 8: Microbes in Production of Fine Chemicals (Antibiotics, Drugs, Vitamins, and Amino Acids)". Applied Microbiology. Springer India. pp. 83–120. doi:10.1007/978-81-322-2259-0. ISBN 978-81-322-2258-3. S2CID 36527513.
- ↑ Foster W, Raoult A (December 1974). "Early descriptions of antibiosis". The Journal of the Royal College of General Practitioners. 24 (149): 889–894. PMC 2157443. PMID 4618289.
- ↑ Landsberg H (1949). "Prelude to the discovery of penicillin". Isis. 40 (3): 225–7. doi:10.1086/349043. S2CID 143223535.
- ↑ Waksman SA (1947). "What is an antibiotic or an antibiotic substance?". Mycologia. 39 (5): 565–569. doi:10.1080/00275514.1947.12017635. PMID 20264541.
- ↑ Waksman SA (1947). "What is an antibiotic or an antibiotic substance?". Mycologia. 39 (5): 565–9. doi:10.2307/3755196. JSTOR 3755196. PMID 20264541.
- ↑ Scholar EM, Pratt WB (2000). The Antimicrobial Drugs. Oxford University Press, US. pp. 3. ISBN 978-0-19-512529-0.
- ↑ Davies J, Davies D (September 2010). "Origins and evolution of antibiotic resistance". Microbiology and Molecular Biology Reviews. 74 (3): 417–33. doi:10.1128/MMBR.00016-10. PMC 2937522. PMID 20805405.
- ↑ Liddell HG, Scott R (eds.). "βιωτικός". A Greek-English Lexicon. Archived from the original on 25 April 2023. Retrieved 20 February 2021 – via Perseus Project.
- ↑ Liddell HG, Scott R (eds.). "βίωσις". A Greek-English Lexicon. Archived from the original on 25 February 2021. Retrieved 20 February 2021 – via Perseus Project.
- 1 2 "Antibiotics FAQ". McGill University, Canada. Archived from the original on 16 February 2008. Retrieved 17 February 2008.
- ↑ Liddell HG, Scott R (eds.). "βίος". A Greek-English Lexicon. Archived from the original on 27 February 2021. Retrieved 20 February 2021 – via Perseus Project.
- ↑ Liddell HG, Scott R (eds.). "ἀντί". A Greek-English Lexicon. Archived from the original on 10 October 2012. Retrieved 20 February 2021 – via Perseus Project.
- ↑ Liddell HG, Scott R (eds.). "βακτηρία". A Greek-English Lexicon. Archived from the original on 24 February 2021. Retrieved 20 February 2021 – via Perseus Project.
- ↑ bacterial Archived 27 August 2021 at the Wayback Machine, on Oxford Dictionaries
- 1 2 3 Antibiotics Simplified. Jones & Bartlett Publishers. 2011. pp. 15–17. ISBN 978-1-4496-1459-1.
- 1 2 3 4 Leekha S, Terrell CL, Edson RS (February 2011). "General principles of antimicrobial therapy". Mayo Clinic Proceedings. 86 (2): 156–67. doi:10.4065/mcp.2010.0639. PMC 3031442. PMID 21282489.
- ↑ Rollins KE, Varadhan KK, Neal KR, Lobo DN (October 2016). "Antibiotics Versus Appendicectomy for the Treatment of Uncomplicated Acute Appendicitis: An Updated Meta-Analysis of Randomised Controlled Trials". World Journal of Surgery. 40 (10): 2305–18. doi:10.1007/s00268-016-3561-7. PMID 27199000. S2CID 4802473.
- ↑ Flowers CR, Seidenfeld J, Bow EJ, Karten C, Gleason C, Hawley DK, et al. (February 2013). "Antimicrobial prophylaxis and outpatient management of fever and neutropenia in adults treated for malignancy: American Society of Clinical Oncology clinical practice guideline". Journal of Clinical Oncology. 31 (6): 794–810. doi:10.1200/JCO.2012.45.8661. PMID 23319691.
- ↑ Bow EJ (July 2013). "Infection in neutropenic patients with cancer". Critical Care Clinics. 29 (3): 411–41. doi:10.1016/j.ccc.2013.03.002. PMID 23830647.
- ↑ Sethi NJ, Safi S, Korang SK, Hróbjartsson A, Skoog M, Gluud C, Jakobsen JC, et al. (Cochrane Heart Group) (February 2021). "Antibiotics for secondary prevention of coronary heart disease". The Cochrane Database of Systematic Reviews. 2 (5): CD003610. doi:10.1002/14651858.CD003610.pub4. PMC 8094925. PMID 33704780.
- ↑ Pangilinan R, Tice A, Tillotson G (October 2009). "Topical antibiotic treatment for uncomplicated skin and skin structure infections: review of the literature". Expert Review of Anti-Infective Therapy. 7 (8): 957–65. doi:10.1586/eri.09.74. PMID 19803705. S2CID 207217730.
- 1 2 Lipsky BA, Hoey C (November 2009). "Topical antimicrobial therapy for treating chronic wounds". Clinical Infectious Diseases. 49 (10): 1541–9. doi:10.1086/644732. PMID 19842981.
- ↑ Heal CF, Banks JL, Lepper PD, Kontopantelis E, van Driel ML (November 2016). "Topical antibiotics for preventing surgical site infection in wounds healing by primary intention". The Cochrane Database of Systematic Reviews. 2016 (11): CD011426. doi:10.1002/14651858.CD011426.pub2. PMC 6465080. PMID 27819748.
- ↑ Hung KK, Lam RP, Lo RS, Tenney JW, Yang ML, Tai MC, Graham CA (December 2018). "Cross-sectional study on emergency department management of sepsis". Hong Kong Medical Journal = Xianggang Yi Xue Za Zhi. 24 (6): 571–578. doi:10.12809/hkmj177149. PMID 30429360.
- ↑ "UK antibiotic consumption twice that of the Netherlands, WHO report finds". Pharmaceutical Journal. 14 November 2018. Archived from the original on 22 December 2018. Retrieved 22 December 2018.
- 1 2 Slama TG, Amin A, Brunton SA, File TM, Milkovich G, Rodvold KA, et al. (July 2005). "A clinician's guide to the appropriate and accurate use of antibiotics: the Council for Appropriate and Rational Antibiotic Therapy (CARAT) criteria". The American Journal of Medicine. 118 (7A): 1S–6S. doi:10.1016/j.amjmed.2005.05.007. PMID 15993671.
- ↑ Slama TG, Amin A, Brunton SA, File TM, Milkovich G, Rodvold KA, et al. (Council for Appropriate Rational Antibiotic Therapy (CARAT)) (July 2005). "A clinician's guide to the appropriate and accurate use of antibiotics: the Council for Appropriate and Rational Antibiotic Therapy (CARAT) criteria". The American Journal of Medicine. 118 (7A): 1S–6S. doi:10.1016/j.amjmed.2005.05.007. PMID 15993671.
- ↑ "Antibiotics – Side effects". NHS Choices. National Health Service (NHS), UK. 6 May 2014. Archived from the original on 7 February 2016. Retrieved 6 February 2016.
- ↑ "Antibiotic-Associated Diarrhea – All you should know". Archived from the original on 25 April 2015. Retrieved 28 December 2014.
- ↑ Rodgers B, Kirley K, Mounsey A (March 2013). "PURLs: prescribing an antibiotic? Pair it with probiotics". The Journal of Family Practice. 62 (3): 148–50. PMC 3601687. PMID 23520586.
- ↑ Pirotta MV, Garland SM (September 2006). "Genital Candida species detected in samples from women in Melbourne, Australia, before and after treatment with antibiotics". Journal of Clinical Microbiology. 44 (9): 3213–7. doi:10.1128/JCM.00218-06. PMC 1594690. PMID 16954250.
- ↑ Lewis T, Cook J (1 January 2014). "Fluoroquinolones and tendinopathy: a guide for athletes and sports clinicians and a systematic review of the literature". Journal of Athletic Training. 49 (3): 422–7. doi:10.4085/1062-6050-49.2.09. PMC 4080593. PMID 24762232.
- ↑ Marchant J (March 2018). "When antibiotics turn toxic". Nature. 555 (7697): 431–433. Bibcode:2018Natur.555..431M. doi:10.1038/d41586-018-03267-5. PMID 29565407.
- ↑ Wang X, Ryu D, Houtkooper RH, Auwerx J (October 2015). "Antibiotic use and abuse: a threat to mitochondria and chloroplasts with impact on research, health, and environment". BioEssays. 37 (10): 1045–53. doi:10.1002/bies.201500071. PMC 4698130. PMID 26347282.
- 1 2 3 4 Anderson KC, Schwartz MD, Lieu SO (January 2013). "Antibiotics and OC effectiveness". JAAPA. 26 (1): 11. doi:10.1097/01720610-201301000-00002. PMID 23355994.
- 1 2 3 Weaver K, Glasier A (February 1999). "Interaction between broad-spectrum antibiotics and the combined oral contraceptive pill. A literature review". Contraception. 59 (2): 71–8. doi:10.1016/S0010-7824(99)00009-8. PMID 10361620.
- ↑ Weisberg E (May 1999). "Interactions between oral contraceptives and antifungals/antibacterials. Is contraceptive failure the result?". Clinical Pharmacokinetics. 36 (5): 309–13. doi:10.2165/00003088-199936050-00001. PMID 10384856. S2CID 25187892.
- ↑ Hassan T (March 1987). "Pharmacologic considerations for patients taking oral contraceptives". Connecticut Dental Student Journal. 7: 7–8. PMID 3155374.
- ↑ Orme ML, Back DJ (December 1990). "Factors affecting the enterohepatic circulation of oral contraceptive steroids". American Journal of Obstetrics and Gynecology. 163 (6 Pt 2): 2146–52. doi:10.1016/0002-9378(90)90555-L. PMID 2256523. Archived from the original on 13 July 2015. Retrieved 11 March 2009.
- ↑ Lwanga J, Mears, Bingham JS, Bradbeer CS (2008). "Do antibiotics and alcohol mix? The beliefs of genitourinary clinic attendees". BMJ. 337: a2885. doi:10.1136/bmj.a2885. S2CID 58765542.
- ↑ "antibiotics-and-alcohol". Archived from the original on 12 June 2011., Mayo Clinic
- 1 2 "Can I drink alcohol while taking antibiotics?". NHS Direct (UK electronic health service). Archived from the original on 24 October 2010. Retrieved 17 February 2008.
- ↑ Moore AA, Whiteman EJ, Ward KT (March 2007). "Risks of combined alcohol/medication use in older adults". The American Journal of Geriatric Pharmacotherapy. 5 (1): 64–74. doi:10.1016/j.amjopharm.2007.03.006. PMC 4063202. PMID 17608249.
- ↑ Stockley IH (2002). Stockley's Drug Interactions (6th ed.). London: Pharmaceutical Press.
- 1 2 3 Pankey GA, Sabath LD (March 2004). "Clinical relevance of bacteriostatic versus bactericidal mechanisms of action in the treatment of Gram-positive bacterial infections". Clinical Infectious Diseases. 38 (6): 864–70. doi:10.1086/381972. PMID 14999632.
- ↑ Mascio CT, Alder JD, Silverman JA (December 2007). "Bactericidal action of daptomycin against stationary-phase and nondividing Staphylococcus aureus cells". Antimicrobial Agents and Chemotherapy. 51 (12): 4255–60. doi:10.1128/AAC.00824-07. PMC 2167999. PMID 17923487.
- ↑ Pelczar MJ, Chan EC, Krieg NR (2010). "Host-Parasite Interaction; Nonspecific Host Resistance". Microbiology Concepts and Applications (6th ed.). New York: McGraw-Hill. pp. 478–479.
- ↑ Rhee KY, Gardiner DF (September 2004). "Clinical relevance of bacteriostatic versus bactericidal activity in the treatment of gram-positive bacterial infections". Clinical Infectious Diseases. 39 (5): 755–6. doi:10.1086/422881. PMID 15356797.
- ↑ Wiegand I, Hilpert K, Hancock RE (January 2008). "Agar and broth dilution methods to determine the minimal inhibitory concentration (MIC) of antimicrobial substances". Nature Protocols. 3 (2): 163–75. doi:10.1038/nprot.2007.521. PMID 18274517. S2CID 3344950.
- ↑ Dalhoff A, Ambrose PG, Mouton JW (August 2009). "A long journey from minimum inhibitory concentration testing to clinically predictive breakpoints: deterministic and probabilistic approaches in deriving breakpoints". Infection. 37 (4): 296–305. doi:10.1007/s15010-009-7108-9. PMID 19629383. S2CID 20538901.
- 1 2 3 4 Ocampo PS, Lázár V, Papp B, Arnoldini M, Abel zur Wiesch P, Busa-Fekete R, et al. (August 2014). "Antagonism between bacteriostatic and bactericidal antibiotics is prevalent". Antimicrobial Agents and Chemotherapy. 58 (8): 4573–82. doi:10.1128/AAC.02463-14. PMC 4135978. PMID 24867991.
- 1 2 Bollenbach T (October 2015). "Antimicrobial interactions: mechanisms and implications for drug discovery and resistance evolution". Current Opinion in Microbiology. 27: 1–9. doi:10.1016/j.mib.2015.05.008. PMID 26042389.
- ↑ Antonello RM, Principe L, Maraolo AE, Viaggi V, Pol R, Fabbiani M, et al. (August 2020). "Fosfomycin as Partner Drug for Systemic Infection Management. A Systematic Review of Its Synergistic Properties from In Vitro and In Vivo Studies". Antibiotics. 9 (8): 500. doi:10.3390/antibiotics9080500. PMC 7460049. PMID 32785114.
- ↑ "antagonism". Archived from the original on 26 August 2014. Retrieved 25 August 2014.
- ↑ Drawz SM, Bonomo RA (January 2010). "Three decades of beta-lactamase inhibitors". Clinical Microbiology Reviews. 23 (1): 160–201. doi:10.1128/CMR.00037-09. PMC 2806661. PMID 20065329.
- ↑ Finberg RW, Moellering RC, Tally FP, Craig WA, Pankey GA, Dellinger EP, et al. (November 2004). "The importance of bactericidal drugs: future directions in infectious disease". Clinical Infectious Diseases. 39 (9): 1314–20. doi:10.1086/425009. PMID 15494908.
- ↑ Cunha BA (2009). Antibiotic Essentials. Jones & Bartlett Learning. p. 180. ISBN 978-0-7637-7219-2.
- ↑ Srivastava A, Talaue M, Liu S, Degen D, Ebright RY, Sineva E, et al. (October 2011). "New target for inhibition of bacterial RNA polymerase: 'switch region'". Current Opinion in Microbiology. 14 (5): 532–43. doi:10.1016/j.mib.2011.07.030. PMC 3196380. PMID 21862392.
- 1 2 von Nussbaum F, Brands M, Hinzen B, Weigand S, Häbich D (August 2006). "Antibacterial natural products in medicinal chemistry--exodus or revival?". Angewandte Chemie. 45 (31): 5072–129. doi:10.1002/anie.200600350. PMID 16881035.
- ↑ Dougherty TJ, Pucci MJ (2011). Antibiotic Discovery and Development. Springer. p. 800. ISBN 978-1-4614-1400-1.
- ↑ Fedorenko V, Genilloud O, Horbal L, Marcone GL, Marinelli F, Paitan Y, Ron EZ (2015). "Antibacterial Discovery and Development: From Gene to Product and Back". BioMed Research International. 2015: 591349. doi:10.1155/2015/591349. PMC 4538407. PMID 26339625.
- ↑ Sample I (26 March 2018). "Calls to rein in antibiotic use after study shows 65% increase worldwide". The Guardian. Archived from the original on 8 April 2018. Retrieved 28 March 2018.
- ↑ Levy SB (October 1994). "Balancing the drug-resistance equation". Trends in Microbiology. 2 (10): 341–2. doi:10.1016/0966-842X(94)90607-6. PMID 7850197.
- ↑ Luria SE, Delbrück M (November 1943). "Mutations of Bacteria from Virus Sensitivity to Virus Resistance". Genetics. 28 (6): 491–511. doi:10.1093/genetics/28.6.491. PMC 1209226. PMID 17247100.
- 1 2 Pearson C (28 February 2007). "Antibiotic Resistance Fast-Growing Problem Worldwide". Voice of America. Archived from the original on 2 December 2008. Retrieved 29 December 2008.
- ↑ Topp E, Chapman R, Devers-Lamrani M, Hartmann A, Marti R, Martin-Laurent F, et al. (2013). "Accelerated Biodegradation of Veterinary Antibiotics in Agricultural Soil following Long-Term Exposure, and Isolation of a Sulfamethazine-degrading sp". Journal of Environmental Quality. 42 (1): 173–8. doi:10.2134/jeq2012.0162. PMID 23673752. Archived from the original on 12 December 2013. Retrieved 22 November 2013.
- 1 2 3 Witte W (September 2004). "International dissemination of antibiotic resistant strains of bacterial pathogens". Infection, Genetics and Evolution. 4 (3): 187–91. doi:10.1016/j.meegid.2003.12.005. PMID 15450197.
- ↑ Dyer BD (2003). "Chapter 9, Pathogens". A Field Guide To Bacteria. Cornell University Press. ISBN 978-0-8014-8854-2.
- ↑ Andersson DI (October 2006). "The biological cost of mutational antibiotic resistance: any practical conclusions?". Current Opinion in Microbiology. 9 (5): 461–5. doi:10.1016/j.mib.2006.07.002. PMID 16890008.
- ↑ D'Costa VM, King CE, Kalan L, Morar M, Sung WW, Schwarz C, et al. (August 2011). "Antibiotic resistance is ancient". Nature. 477 (7365): 457–61. Bibcode:2011Natur.477..457D. doi:10.1038/nature10388. PMID 21881561. S2CID 4415610.
- ↑ Gladki A, Kaczanowski S, Szczesny P, Zielenkiewicz P (February 2013). "The evolutionary rate of antibacterial drug targets". BMC Bioinformatics. 14 (1): 36. doi:10.1186/1471-2105-14-36. PMC 3598507. PMID 23374913.
- 1 2 Alekshun MN, Levy SB (March 2007). "Molecular mechanisms of antibacterial multidrug resistance". Cell. 128 (6): 1037–50. doi:10.1016/j.cell.2007.03.004. PMID 17382878. S2CID 18343252.
- ↑ Pawlowski AC, Wang W, Koteva K, Barton HA, McArthur AG, Wright GD (December 2016). "A diverse intrinsic antibiotic resistome from a cave bacterium". Nature Communications. 7: 13803. Bibcode:2016NatCo...713803P. doi:10.1038/ncomms13803. PMC 5155152. PMID 27929110.
- ↑ Marshall CG, Lessard IA, Park I, Wright GD (September 1998). "Glycopeptide antibiotic resistance genes in glycopeptide-producing organisms". Antimicrobial Agents and Chemotherapy. 42 (9): 2215–20. doi:10.1128/AAC.42.9.2215. PMC 105782. PMID 9736537.
- ↑ Nikaido H (February 2009). "Multidrug resistance in bacteria". Annual Review of Biochemistry. 78 (1): 119–46. doi:10.1146/annurev.biochem.78.082907.145923. PMC 2839888. PMID 19231985.
- 1 2 3 Baker-Austin C, Wright MS, Stepanauskas R, McArthur JV (April 2006). "Co-selection of antibiotic and metal resistance". Trends in Microbiology. 14 (4): 176–82. doi:10.1016/j.tim.2006.02.006. PMID 16537105.
- ↑ "Health ministers to accelerate efforts against drug-resistant TB". World Health Organization (WHO).
- ↑ Boseley S (12 August 2010). "Are you ready for a world without antibiotics?". The Guardian. London. Archived from the original on 30 November 2010.
- ↑ "Multi-resistant hospital bacteria linked to India and Pakistan". Health Protection Report. Health Protection Agency. 3 July 2009. Archived from the original on 14 July 2014. Retrieved 16 August 2010.
- ↑ McGann P, Snesrud E, Maybank R, Corey B, Ong AC, Clifford R, et al. (July 2016). "Escherichia coli Harboring mcr-1 and blaCTX-M on a Novel IncF Plasmid: First Report of mcr-1 in the United States". Antimicrobial Agents and Chemotherapy. 60 (7): 4420–1. doi:10.1128/AAC.01103-16. PMC 4914657. PMID 27230792.
- ↑ Moyer MW (27 May 2016). "Dangerous New Antibiotic-Resistant Bacteria Reach U.S." Scientific American. Archived from the original on 28 July 2020. Retrieved 27 May 2016.
- ↑ Di Bella S, Antonello RM, Sanson G, Maraolo AE, Giacobbe DR, Sepulcri C, et al. (June 2022). "Anaerobic bloodstream infections in Italy (ITANAEROBY): A 5-year retrospective nationwide survey". Anaerobe. 75: 102583. doi:10.1016/j.anaerobe.2022.102583. hdl:11368/3020691. PMID 35568274. S2CID 248736289.
- ↑ Marino PL (2007). "Antimicrobial therapy". The ICU book. Hagerstown, MD: Lippincott Williams & Wilkins. p. 817. ISBN 978-0-7817-4802-5.
- 1 2 Arulkumaran N, Routledge M, Schlebusch S, Lipman J, Conway Morris A (February 2020). "Antimicrobial-associated harm in critical care: a narrative review". Intensive Care Medicine. 46 (2): 225–235. doi:10.1007/s00134-020-05929-3. PMC 7046486. PMID 31996961.
- 1 2 3 Larson E (2007). "Community factors in the development of antibiotic resistance". Annual Review of Public Health. 28 (1): 435–47. doi:10.1146/annurev.publhealth.28.021406.144020. PMID 17094768.
- 1 2 Hawkey PM (September 2008). "The growing burden of antimicrobial resistance". The Journal of Antimicrobial Chemotherapy. 62 (Supplement 1): i1-9. CiteSeerX 10.1.1.629.3960. doi:10.1093/jac/dkn241. PMID 18684701.
- ↑ Ong S, Nakase J, Moran GJ, Karras DJ, Kuehnert MJ, Talan DA (September 2007). "Antibiotic use for emergency department patients with upper respiratory infections: prescribing practices, patient expectations, and patient satisfaction". Annals of Emergency Medicine. 50 (3): 213–20. doi:10.1016/j.annemergmed.2007.03.026. PMID 17467120.
- ↑ Metlay JP, Camargo CA, MacKenzie T, McCulloch C, Maselli J, Levin SK, et al. (September 2007). "Cluster-randomized trial to improve antibiotic use for adults with acute respiratory infections treated in emergency departments". Annals of Emergency Medicine. 50 (3): 221–30. doi:10.1016/j.annemergmed.2007.03.022. PMID 17509729.
- ↑ Coxeter P, Del Mar CB, McGregor L, Beller EM, Hoffmann TC (November 2015). "Interventions to facilitate shared decision making to address antibiotic use for acute respiratory infections in primary care". The Cochrane Database of Systematic Reviews. 11 (11): CD010907. doi:10.1002/14651858.CD010907.pub2. PMC 6464273. PMID 26560888.
- ↑ Mendelson M, Røttingen JA, Gopinathan U, Hamer DH, Wertheim H, Basnyat B, et al. (January 2016). "Maximising access to achieve appropriate human antimicrobial use in low-income and middle-income countries". Lancet. 387 (10014): 188–98. doi:10.1016/S0140-6736(15)00547-4. PMID 26603919. S2CID 13904240.
- ↑ " Archived 27 December 2017 at the Wayback Machine." Centers for Disease Control and Prevention. Retrieved 12 March 2009.
- ↑ "Keep Antibiotics Working". Keep Antibiotics Working. Archived from the original on 24 October 2010. Retrieved 21 May 2010.
- ↑ Sabuncu E, David J, Bernède-Bauduin C, Pépin S, Leroy M, Boëlle PY, et al. (June 2009). Klugman KP (ed.). "Significant reduction of antibiotic use in the community after a nationwide campaign in France, 2002-2007". PLOS Medicine. 6 (6): e1000084. doi:10.1371/journal.pmed.1000084. PMC 2683932. PMID 19492093.
- ↑ "Regulation (EC) No 1831/2003 of the European Parliament and of the Council". Archived from the original on 9 January 2009.
- ↑ "The Overuse of Antibiotics in Food Animals Threatens Public Health". Consumer Reports. Archived from the original on 28 June 2016. Retrieved 4 July 2016.
- 1 2 "Preservation of Antibiotics for Medical Treatment Act of 2005 (2005 - S. 742)". GovTrack.us. Archived from the original on 15 April 2019. Retrieved 15 April 2019.
- 1 2 "Preservation of Antibiotics for Medical Treatment Act of 2005 (2005 - H.R. 2562)". GovTrack.us. Archived from the original on 15 April 2019. Retrieved 15 April 2019.
- ↑ "Kee Antibiotics Working" (PDF). Archived from the original (PDF) on 25 March 2009. Retrieved 12 November 2008.
- ↑ "The Preservation of Antibiotics for Medical Treatment Act of 2005 (S. 742/H.R. 2562)" (PDF). The Institute for Agriculture and Trade Policy. Archived (PDF) from the original on 30 October 2020. Retrieved 4 October 2020.
- ↑ Charles D (22 December 2016). "Despite Pledges To Cut Back, Farms Are Still Using Antibiotics". NPR. Archived from the original on 26 July 2020. Retrieved 5 April 2018.
- ↑ Gever J (23 March 2012). "FDA Told to Move on Antibiotic Use in Livestock". MedPage Today. Archived from the original on 27 April 2021. Retrieved 24 March 2012.
- ↑ Barnes S. "Rutgers study finds antibiotic overuse is caused by misconceptions, financial incentives". The Daily Targum. Archived from the original on 6 December 2021. Retrieved 16 February 2021.
- ↑ Blaser MJ, Melby MK, Lock M, Nichter M (February 2021). "Accounting for variation in and overuse of antibiotics among humans". BioEssays. 43 (2): e2000163. doi:10.1002/bies.202000163. PMID 33410142. S2CID 230811912. Archived from the original on 16 February 2021. Retrieved 16 February 2021.
- ↑ Kalghatgi S, Spina CS, Costello JC, Liesa M, Morones-Ramirez JR, Slomovic S, et al. (July 2013). "Bactericidal antibiotics induce mitochondrial dysfunction and oxidative damage in Mammalian cells". Science Translational Medicine. 5 (192): 192ra85. doi:10.1126/scitranslmed.3006055. PMC 3760005. PMID 23825301.
- ↑ Singer M (January 2014). "The role of mitochondrial dysfunction in sepsis-induced multi-organ failure". Virulence. 5 (1): 66–72. doi:10.4161/viru.26907. PMC 3916385. PMID 24185508.
- ↑ Alagna L, Bandera A, Patruno A, Muscatello A, Citerio G, Gori A (May 2019). "Microbiota in ICU, not only a gut problem". Intensive Care Medicine. 45 (5): 733–737. doi:10.1007/s00134-018-05516-7. PMID 30671622. S2CID 58949829.
- ↑ Lindblad WJ (June 2008). "Considerations for determining if a natural product is an effective wound-healing agent". The International Journal of Lower Extremity Wounds. 7 (2): 75–81. doi:10.1177/1534734608316028. PMID 18483011. S2CID 5059255.
- ↑ Forrest RD (March 1982). "Early history of wound treatment". Journal of the Royal Society of Medicine. 75 (3): 198–205. doi:10.1177/014107688207500310. PMC 1437561. PMID 7040656.
- ↑ Wainwright M (1989). "Moulds in ancient and more recent medicine". Mycologist. 3 (1): 21–23. doi:10.1016/S0269-915X(89)80010-2.
- ↑ Armelagos, George (2000). "Take Two Beers and Call Me in 1,600 Years: Use of Tetracycline by Nubians and Ancient Egyptians" (PDF). Natural History (5, May): 50–53. Retrieved 13 March 2017.
- 1 2 Limbird LE (December 2004). "The receptor concept: a continuing evolution". Molecular Interventions. 4 (6): 326–36. doi:10.1124/mi.4.6.6. PMID 15616162.
- 1 2 3 Bosch F, Rosich L (2008). "The contributions of Paul Ehrlich to pharmacology: a tribute on the occasion of the centenary of his Nobel Prize". Pharmacology. 82 (3): 171–9. doi:10.1159/000149583. PMC 2790789. PMID 18679046.
- 1 2 Williams KJ (August 2009). "The introduction of 'chemotherapy' using arsphenamine - the first magic bullet". Journal of the Royal Society of Medicine. 102 (8): 343–348. doi:10.1258/jrsm.2009.09k036. PMC 2726818. PMID 19679737.
- 1 2 3 Goodman LS, Gilman A (1941). The Pharmacological Basis of Therapeutics. New York: Macmillan.
- ↑ Chouhan S, Sharma K, Guleria S (August 2017). "Antimicrobial Activity of Some Essential Oils-Present Status and Future Perspectives". Medicines. 4 (3): 58. doi:10.3390/medicines4030058. PMC 5622393. PMID 28930272.
- ↑ Cowan MM (October 1999). "Plant products as antimicrobial agents". Clinical Microbiology Reviews. 12 (4): 564–582. doi:10.1128/CMR.12.4.564. PMC 88925. PMID 10515903.
- 1 2 Frith J. "Arsenic – the "Poison of Kings" and the "Saviour of Syphilis"". Journal of Military and Veterans' Health. 21 (4). Archived from the original on 26 February 2017. Retrieved 31 January 2017.
- ↑ "The Nobel Prize in Physiology or Medicine 1908". NobelPrize.org. Archived from the original on 14 August 2018. Retrieved 13 June 2017.
- ↑ "Nomination Archive". NobelPrize.org. April 2020. Archived from the original on 26 July 2020. Retrieved 13 June 2017.
- 1 2 Aminov RI (2010). "A brief history of the antibiotic era: lessons learned and challenges for the future". Frontiers in Microbiology. 1: 134. doi:10.3389/fmicb.2010.00134. PMC 3109405. PMID 21687759.
- ↑ "Physiology or Medicine 1939 – Presentation Speech". Nobel Foundation. Archived from the original on 14 January 2015. Retrieved 14 January 2015.
- ↑ Wright PM, Seiple IB, Myers AG (August 2014). "The evolving role of chemical synthesis in antibacterial drug discovery". Angewandte Chemie. 53 (34): 8840–69. doi:10.1002/anie.201310843. PMC 4536949. PMID 24990531.
- ↑ Aminov RI (1 January 2010). "A brief history of the antibiotic era: lessons learned and challenges for the future". Frontiers in Microbiology. 1: 134. doi:10.3389/fmicb.2010.00134. PMC 3109405. PMID 21687759.
- ↑ Kingston W (June 2008). "Irish contributions to the origins of antibiotics". Irish Journal of Medical Science. 177 (2): 87–92. doi:10.1007/s11845-008-0139-x. PMID 18347757. S2CID 32847260.
- ↑ Foster W, Raoult A (December 1974). "Early descriptions of antibiosis". The Journal of the Royal College of General Practitioners. 24 (149): 889–94. PMC 2157443. PMID 4618289.
the first scientific observations of the antagonistic actions of various micro-organisms were made ... by William Roberts of Manchester (1874) and John Tyndall of London (1876).
- ↑ Bucci R, Gallì P (11 May 2012). "Public Health History Corner Vincenzo Tiberio: a misunderstood researcher". Italian Journal of Public Health. 8 (4). Archived from the original on 20 September 2018. Retrieved 30 September 2017.
- ↑ Duchesne E (23 September 2017). Duchesne's Antagonism between molds and bacteria, an English Colloquial Translation. Translated by Witty M. Independently Published. ISBN 978-1-5498-1696-3.
- 1 2 Straand J, Gradmann C, Simonsen GS, Lindbæk M (2008). International Encyclopedia of Public Health: Antibiotic Development and Resistance. Academic Press. p. 200. Archived from the original on 4 October 2016. Retrieved 31 January 2017.
- ↑ Pathak A, Nowell RW, Wilson CG, Ryan MJ, Barraclough TG (September 2020). "Comparative genomics of Alexander Fleming's original Penicillium isolate (IMI 15378) reveals sequence divergence of penicillin synthesis genes". Scientific Reports. 10 (1): Article 15705. Bibcode:2020NatSR..1015705P. doi:10.1038/s41598-020-72584-5. PMC 7515868. PMID 32973216.
- ↑ Tan SY, Tatsumura Y (July 2015). "Alexander Fleming (1881-1955): Discoverer of penicillin". Singapore Medical Journal. 56 (7): 366–7. doi:10.11622/smedj.2015105. PMC 4520913. PMID 26243971.
- ↑ Fleming A (1980). "Classics in infectious diseases: on the antibacterial action of cultures of a penicillium, with special reference to their use in the isolation of B. influenzae by Alexander Fleming, Reprinted from the British Journal of Experimental Pathology 10:226-236, 1929". Reviews of Infectious Diseases. 2 (1): 129–39. doi:10.1093/clinids/2.1.129. PMC 2041430. PMID 6994200.; Reprint of Krylov AK (929). "[Gastroenterologic aspects of the clinical picture of internal diseases]". Terapevticheskii Arkhiv. 63 (2): 139–41. PMID 2048009.
- ↑ Sykes R (2001). "Penicillin: from discovery to product". Bulletin of the World Health Organization. 79 (8): 778–9. PMC 2566502. PMID 11545336.
- ↑ Jones DS, Jones JH (1 December 2014). "Sir Edward Penley Abraham CBE. 10 June 1913 – 9 May 1999". Biographical Memoirs of Fellows of the Royal Society. 60: 5–22. doi:10.1098/rsbm.2014.0002. ISSN 0080-4606.
- ↑ Florey HW (November 1945). "Use of Micro-organisms for Therapeutic Purposes". British Medical Journal. 2 (4427): 635–42. doi:10.1136/bmj.2.4427.635. PMC 2060276. PMID 20786386.
- ↑ "The Nobel Prize in Physiology or Medicine 1945". The Nobel Prize Organization. Archived from the original on 23 May 2020. Retrieved 13 January 2018.
- 1 2 Van Epps HL (February 2006). "René Dubos: unearthing antibiotics". The Journal of Experimental Medicine. 203 (2): 259. doi:10.1084/jem.2032fta. PMC 2118194. PMID 16528813.
- ↑ Capocci M (1 January 2014). "Cold drugs. Circulation, production and intelligence of antibiotics in post-WWII years". Medicina Nei Secoli. 26 (2): 401–21. PMID 26054208.
- ↑ Conly J, Johnston B (May 2005). "Where are all the new antibiotics? The new antibiotic paradox". The Canadian Journal of Infectious Diseases & Medical Microbiology. 16 (3): 159–60. doi:10.1155/2005/892058. PMC 2095020. PMID 18159536.
- 1 2 3 Antibacterial agents in clinical development: an analysis of the antibacterial clinical development pipeline, including tuberculosis. Geneva: World Health Organization; 2017 (WHO/EMP/IAU/2017.12). Licence: CC BY-NC-SA 3.0 IGO.
- ↑ Boucher HW, Talbot GH, Benjamin DK, Bradley J, Guidos RJ, Jones RN, et al. (June 2013). "10 x '20 Progress--development of new drugs active against gram-negative bacilli: an update from the Infectious Diseases Society of America". Clinical Infectious Diseases. 56 (12): 1685–94. doi:10.1093/cid/cit152. PMC 3707426. PMID 23599308.
- ↑ Steenhuysen J (18 April 2013). "Drug pipeline for worst superbugs 'on life support': report". Reuters. Archived from the original on 25 December 2015. Retrieved 23 June 2013.
- 1 2 Boucher HW, Talbot GH, Benjamin DK, Bradley J, Guidos RJ, Jones RN, et al. (June 2013). Infectious Diseases Society of America. "10 x '20 Progress--development of new drugs active against gram-negative bacilli: an update from the Infectious Diseases Society of America". Clinical Infectious Diseases. 56 (12): 1685–94. doi:10.1093/cid/cit152. PMC 3707426. PMID 23599308.
- ↑ Liu J, Bedell TA, West JG, Sorensen EJ (June 2016). "Design and Synthesis of Molecular Scaffolds with Anti-infective Activity". Tetrahedron. 72 (25): 3579–3592. doi:10.1016/j.tet.2016.01.044. PMC 4894353. PMID 27284210.
- 1 2 3 Fernandes P, Martens E (June 2017). "Antibiotics in late clinical development". Biochemical Pharmacology. 133: 152–163. doi:10.1016/j.bcp.2016.09.025. PMID 27687641.
- 1 2 3 4 5 6 7 8 9 Butler MS, Paterson DL (June 2020). "Antibiotics in the clinical pipeline in October 2019". The Journal of Antibiotics. 73 (6): 329–364. doi:10.1038/s41429-020-0291-8. PMC 7223789. PMID 32152527.
- ↑ Zampaloni, C; Mattei, P; Bleicher, K; Winther, L; Thäte, C; Bucher, C; Adam, JM; Alanine, A; Amrein, KE; Baidin, V; Bieniossek, C; Bissantz, C; Boess, F; Cantrill, C; Clairfeuille, T; Dey, F; Di Giorgio, P; du Castel, P; Dylus, D; Dzygiel, P; Felici, A; García-Alcalde, F; Haldimann, A; Leipner, M; Leyn, S; Louvel, S; Misson, P; Osterman, A; Pahil, K; Rigo, S; Schäublin, A; Scharf, S; Schmitz, P; Stoll, T; Trauner, A; Zoffmann, S; Kahne, D; Young, JAT; Lobritz, MA; Bradley, KA (3 January 2024). "A novel antibiotic class targeting the lipopolysaccharide transporter". Nature. doi:10.1038/s41586-023-06873-0. PMID 38172634.
- ↑ Pahil, KS; Gilman, MSA; Baidin, V; Clairfeuille, T; Mattei, P; Bieniossek, C; Dey, F; Muri, D; Baettig, R; Lobritz, M; Bradley, K; Kruse, AC; Kahne, D (3 January 2024). "A new antibiotic traps lipopolysaccharide in its intermembrane transporter". Nature. doi:10.1038/s41586-023-06799-7. PMID 38172635.
- ↑ "Antibiotic Development to Advance Patient Treatment Act of 2013" (PDF). US Congress. 12 December 2013. Archived (PDF) from the original on 9 October 2022.
- ↑ Clarke T (19 September 2014). "U.S. Congress urged to pass bill to speed development of antibiotics". Reuters. Reuters. Archived from the original on 9 December 2015. Retrieved 19 September 2014.
- 1 2 3 Moloney MG (August 2016). "Natural Products as a Source for Novel Antibiotics". Trends in Pharmacological Sciences. 37 (8): 689–701. doi:10.1016/j.tips.2016.05.001. PMID 27267698. S2CID 3537191. Archived from the original on 27 July 2021. Retrieved 25 August 2020.
- 1 2 3 4 5 Cushnie TP, Cushnie B, Echeverría J, Fowsantear W, Thammawat S, Dodgson JL, et al. (June 2020). "Bioprospecting for Antibacterial Drugs: a Multidisciplinary Perspective on Natural Product Source Material, Bioassay Selection and Avoidable Pitfalls". Pharmaceutical Research. 37 (7): 125. doi:10.1007/s11095-020-02849-1. PMID 32529587. S2CID 219590658. Archived from the original on 2 December 2020. Retrieved 17 September 2020.
- ↑ Mashalidis EH, Lee SY (August 2020). "Structures of Bacterial MraY and Human GPT Provide Insights into Rational Antibiotic Design". Journal of Molecular Biology. 432 (18): 4946–4963. doi:10.1016/j.jmb.2020.03.017. PMC 8351759. PMID 32199982.
- ↑ Xia J, Feng B, Wen G, Xue W, Ma G, Zhang H, Wu S (July 2020). "Bacterial Lipoprotein Biosynthetic Pathway as a Potential Target for Structure-based Design of Antibacterial Agents". Current Medicinal Chemistry. 27 (7): 1132–1150. doi:10.2174/0929867325666181008143411. PMID 30360704. S2CID 53097836.
- 1 2 3 4 5 6 7 8 9 10 11 Theuretzbacher U, Piddock LJ (July 2019). "Non-traditional Antibacterial Therapeutic Options and Challenges". Cell Host & Microbe. 26 (1): 61–72. doi:10.1016/j.chom.2019.06.004. PMID 31295426.
- 1 2 3 4 5 6 7 8 9 Ghosh C, Sarkar P, Issa R, Haldar J (April 2019). "Alternatives to Conventional Antibiotics in the Era of Antimicrobial Resistance". Trends in Microbiology. 27 (4): 323–338. doi:10.1016/j.tim.2018.12.010. PMID 30683453. S2CID 59274650.
- ↑ Abedon ST, Kuhl SJ, Blasdel BG, Kutter EM (March 2011). "Phage treatment of human infections". Bacteriophage. 1 (2): 66–85. doi:10.4161/bact.1.2.15845. PMC 3278644. PMID 22334863.
- 1 2 Czaplewski L, Bax R, Clokie M, Dawson M, Fairhead H, Fischetti VA, et al. (February 2016). "Alternatives to antibiotics-a pipeline portfolio review" (PDF). The Lancet. Infectious Diseases. 16 (2): 239–51. doi:10.1016/S1473-3099(15)00466-1. PMID 26795692. S2CID 21677232. Archived (PDF) from the original on 17 August 2019. Retrieved 22 November 2018.
- ↑ Moayyedi P, Yuan Y, Baharith H, Ford AC (August 2017). "Faecal microbiota transplantation for Clostridium difficile-associated diarrhoea: a systematic review of randomised controlled trials". The Medical Journal of Australia. 207 (4): 166–172. doi:10.5694/mja17.00295. PMID 28814204. S2CID 24780848.
- ↑ Vrancianu CO, Gheorghe I, Czobor IB, Chifiriuc MC (June 2020). "Antibiotic Resistance Profiles, Molecular Mechanisms and Innovative Treatment Strategies of Acinetobacter baumannii". Microorganisms. 8 (6): Article 935. doi:10.3390/microorganisms8060935. PMC 7355832. PMID 32575913.
- ↑ Hutchings MI, Truman AW, Wilkinson B (October 2019). "Antibiotics: past, present and future". Current Opinion in Microbiology. 51: 72–80. doi:10.1016/j.mib.2019.10.008. PMID 31733401.
- ↑ Holmes NA, Devine R, Qin Z, Seipke RF, Wilkinson B, Hutchings MI (January 2018). "Complete genome sequence of Streptomyces formicae KY5, the formicamycin producer". Journal of Biotechnology. 265: 116–118. doi:10.1016/j.jbiotec.2017.11.011. PMID 29191667.
- ↑ "hutchingslab Resources and Information". ww3.hutchingslab.uk.
- ↑ Bills GF, Gloer JB, An Z (October 2013). "Coprophilous fungi: antibiotic discovery and functions in an underexplored arena of microbial defensive mutualism". Current Opinion in Microbiology. 16 (5): 549–65. doi:10.1016/j.mib.2013.08.001. PMID 23978412.
- ↑ Kenny CR, Furey A, Lucey B (2015). "A post-antibiotic era looms: can plant natural product research fill the void?". British Journal of Biomedical Science. 72 (4): 191–200. doi:10.1080/09674845.2015.11665752. PMID 26738402. S2CID 41282022.
- ↑ Al-Habib A, Al-Saleh E, Safer AM, Afzal M (June 2010). "Bactericidal effect of grape seed extract on methicillin-resistant Staphylococcus aureus (MRSA)". The Journal of Toxicological Sciences. 35 (3): 357–64. doi:10.2131/jts.35.357. PMID 20519844.
- ↑ Smullen J, Koutsou GA, Foster HA, Zumbé A, Storey DM (2007). "The antibacterial activity of plant extracts containing polyphenols against Streptococcus mutans". Caries Research. 41 (5): 342–9. doi:10.1159/000104791. PMID 17713333. S2CID 44317367.
- 1 2 Monte J, Abreu AC, Borges A, Simões LC, Simões M (June 2014). "Antimicrobial Activity of Selected Phytochemicals against Escherichia coli and Staphylococcus aureus and Their Biofilms". Pathogens. 3 (2): 473–98. doi:10.3390/pathogens3020473. PMC 4243457. PMID 25437810.
- ↑ Tanaka N, Kusama T, Kashiwada Y, Kobayashi J (April 2016). "Bromopyrrole Alkaloids from Okinawan Marine Sponges Agelas spp". Chemical & Pharmaceutical Bulletin. 64 (7): 691–4. doi:10.1248/cpb.c16-00245. PMID 27373625.
- ↑ Cowan MM (October 1999). "Plant products as antimicrobial agents". Clinical Microbiology Reviews. 12 (4): 564–82. doi:10.1128/CMR.12.4.564. PMC 88925. PMID 10515903.
- 1 2 3 Abreu AC, McBain AJ, Simões M (September 2012). "Plants as sources of new antimicrobials and resistance-modifying agents". Natural Product Reports. 29 (9): 1007–21. doi:10.1039/c2np20035j. PMID 22786554.
- ↑ Mahajan GB, Balachandran L (June 2017). "Sources of antibiotics: Hot springs". Biochemical Pharmacology. 134: 35–41. doi:10.1016/j.bcp.2016.11.021. PMID 27890726.
- 1 2 Allison KR, Brynildsen MP, Collins JJ (May 2011). "Metabolite-enabled eradication of bacterial persisters by aminoglycosides". Nature. 473 (7346): 216–20. Bibcode:2011Natur.473..216A. doi:10.1038/nature10069. PMC 3145328. PMID 21562562.
- ↑ Marquez B (December 2005). "Bacterial efflux systems and efflux pumps inhibitors". Biochimie. 87 (12): 1137–47. doi:10.1016/j.biochi.2005.04.012. PMID 15951096.
- ↑ Cushnie TP, Cushnie B, Lamb AJ (November 2014). "Alkaloids: an overview of their antibacterial, antibiotic-enhancing and antivirulence activities". International Journal of Antimicrobial Agents. 44 (5): 377–86. doi:10.1016/j.ijantimicag.2014.06.001. PMID 25130096. S2CID 205171789. Archived from the original on 18 August 2020. Retrieved 19 July 2019.
- 1 2 Molnár J, Engi H, Hohmann J, Molnár P, Deli J, Wesolowska O, et al. (2010). "Reversal of multidrug resistance by natural substances from plants". Current Topics in Medicinal Chemistry. 10 (17): 1757–68. doi:10.2174/156802610792928103. PMID 20645919.
- 1 2 Cushnie TP, Lamb AJ (August 2011). "Recent advances in understanding the antibacterial properties of flavonoids". International Journal of Antimicrobial Agents. 38 (2): 99–107. doi:10.1016/j.ijantimicag.2011.02.014. PMID 21514796. Archived from the original on 26 July 2020. Retrieved 19 July 2019.
- 1 2 Xue L, Chen YY, Yan Z, Lu W, Wan D, Zhu H (July 2019). "Staphyloxanthin: a potential target for antivirulence therapy". Infection and Drug Resistance. 12: 2151–2160. doi:10.2147/IDR.S193649. PMC 6647007. PMID 31410034.
- ↑ Mok N, Chan SY, Liu SY, Chua SL (July 2020). "Vanillin inhibits PqsR-mediated virulence in Pseudomonas aeruginosa". Food & Function. 11 (7): 6496–6508. doi:10.1039/D0FO00046A. hdl:10397/88306. PMID 32697213. S2CID 220699939.
- ↑ Kim HR, Shin DS, Jang HI, Eom YB (August 2020). "Anti-biofilm and anti-virulence effects of zerumbone against Acinetobacter baumannii". Microbiology. 166 (8): 717–726. doi:10.1099/mic.0.000930. PMID 32463353.
- ↑ Plotkin SA, Orenstein WA, Offit PA (2012). Vaccines. Elsevier Health Sciences. pp. 103, 757. ISBN 978-1455700905. Archived from the original on 9 January 2017.
- 1 2 3 Sulakvelidze A, Alavidze Z, Morris JG (March 2001). "Bacteriophage therapy". Antimicrobial Agents and Chemotherapy. 45 (3): 649–59. doi:10.1128/aac.45.3.649-659.2001. PMC 90351. PMID 11181338.
- 1 2 3 4 Gill EE, Franco OL, Hancock RE (January 2015). "Antibiotic adjuvants: diverse strategies for controlling drug-resistant pathogens". Chemical Biology & Drug Design. 85 (1): 56–78. doi:10.1111/cbdd.12478. PMC 4279029. PMID 25393203.
- ↑ Dunne M, Rupf B, Tala M, Qabrati X, Ernst P, Shen Y, et al. (October 2019). "Reprogramming Bacteriophage Host Range through Structure-Guided Design of Chimeric Receptor Binding Proteins". Cell Reports. 29 (5): 1336–1350.e4. doi:10.1016/j.celrep.2019.09.062. hdl:20.500.11850/374453. PMID 31665644. S2CID 204967212.
- ↑ Opal SM (December 2016). "Non-antibiotic treatments for bacterial diseases in an era of progressive antibiotic resistance". Critical Care. 20 (1): 397. doi:10.1186/s13054-016-1549-1. PMC 5159963. PMID 27978847.
- ↑ D'Odorico I, Di Bella S, Monticelli J, Giacobbe DR, Boldock E, Luzzati R (June 2018). "Role of fecal microbiota transplantation in inflammatory bowel disease". Journal of Digestive Diseases. 19 (6): 322–334. doi:10.1111/1751-2980.12603. PMID 29696802. S2CID 24461869.
- ↑ Ishino Y, Krupovic M, Forterre P (April 2018). "History of CRISPR-Cas from Encounter with a Mysterious Repeated Sequence to Genome Editing Technology". Journal of Bacteriology. 200 (7): e00580-17. doi:10.1128/JB.00580-17. PMC 5847661. PMID 29358495.
- ↑ Ritchie, Roser, Mispy, Ortiz-Ospina (2018) "Measuring progress towards the Sustainable Development Goals." (SDG 6) Archived 1 November 2020 at the Wayback Machine SDG-Tracker.org, website
- ↑ "Household crowding". World Health Organization. Archived from the original on 6 January 2021. Retrieved 17 September 2020.
- ↑ Ali SH, Foster T, Hall NL (December 2018). "The Relationship between Infectious Diseases and Housing Maintenance in Indigenous Australian Households". International Journal of Environmental Research and Public Health. 15 (12): Article 2827. doi:10.3390/ijerph15122827. PMC 6313733. PMID 30545014.
- ↑ "Water, sanitation and hygiene links to health". World Health Organization. Archived from the original on 7 September 2020. Retrieved 17 September 2020.
- ↑ Curtis V, Schmidt W, Luby S, Florez R, Touré O, Biran A (April 2011). "Hygiene: new hopes, new horizons". The Lancet. Infectious Diseases. 11 (4): 312–21. doi:10.1016/S1473-3099(10)70224-3. PMC 7106354. PMID 21453872.
- ↑ Gentry EM, Kester S, Fischer K, Davidson LE, Passaretti CL (March 2020). "Bugs and Drugs: Collaboration Between Infection Prevention and Antibiotic Stewardship". Infectious Disease Clinics of North America. 34 (1): 17–30. doi:10.1016/j.idc.2019.10.001. PMID 31836329. S2CID 209358146.
- ↑ Fierens J, Depuydt PO, De Waele JJ (August 2019). "A Practical Approach to Clinical Antibiotic Stewardship in the ICU Patient with Severe Infection". Seminars in Respiratory and Critical Care Medicine. 40 (4): 435–446. doi:10.1055/s-0039-1693995. PMID 31585470. S2CID 203720304.
- ↑ Newman AM, Arshad M (September 2020). "The Role of Probiotics, Prebiotics and Synbiotics in Combating Multidrug-Resistant Organisms". Clinical Therapeutics. 42 (9): 1637–1648. doi:10.1016/j.clinthera.2020.06.011. PMC 7904027. PMID 32800382.
- ↑ Giordano M, Baldassarre ME, Palmieri V, Torres DD, Carbone V, Santangelo L, et al. (May 2019). "Management of STEC Gastroenteritis: Is There a Role for Probiotics?". International Journal of Environmental Research and Public Health. 16 (9): Article 1649. doi:10.3390/ijerph16091649. PMC 6539596. PMID 31083597.
- ↑ Jha R, Das R, Oak S, Mishra P (October 2020). "Probiotics (Direct-Fed Microbials) in Poultry Nutrition and Their Effects on Nutrient Utilization, Growth and Laying Performance, and Gut Health: A Systematic Review". Animals. 10 (10): 1863. doi:10.3390/ani10101863. PMC 7602066. PMID 33066185.
- ↑ Jha R, Mishra P (April 2021). "Dietary fiber in poultry nutrition and their effects on nutrient utilization, performance, gut health, and on the environment: a review". Journal of Animal Science and Biotechnology. 12 (1): 51. doi:10.1186/s40104-021-00576-0. PMC 8054369. PMID 33866972.
- ↑ Beckley AM, Wright ES (October 2021). "Identification of antibiotic pairs that evade concurrent resistance via a retrospective analysis of antimicrobial susceptibility test results". The Lancet. Microbe. 2 (10): e545–e554. doi:10.1016/S2666-5247(21)00118-X. PMC 8496867. PMID 34632433.
- ↑ Ma Y, Chua SL (15 November 2021). "No collateral antibiotic sensitivity by alternating antibiotic pairs". The Lancet Microbe. 3 (1): e7. doi:10.1016/S2666-5247(21)00270-6. ISSN 2666-5247. PMID 35544116. S2CID 244147577.
- ↑ Donald RG, Anderson AS (2011). "Current strategies for antibacterial vaccine development". In Miller PF (ed.). Emerging trends in antibacterial discovery: answering the call to arms. Horizon Scientific Press. p. 283.
- ↑ Miller AA (2011). Miller PF (ed.). Emerging trends in antibacterial discovery: answering the call to arms. Caister Academic Press. ISBN 978-1-904455-89-9.
Further reading
- Gould K (March 2016). "Antibiotics: from prehistory to the present day". The Journal of Antimicrobial Chemotherapy. 71 (3): 572–5. doi:10.1093/jac/dkv484. PMID 26851273.
- Davies J, Davies D (September 2010). "Origins and evolution of antibiotic resistance". Microbiology and Molecular Biology Reviews. 74 (3): 417–33. doi:10.1128/MMBR.00016-10. PMC 2937522. PMID 20805405.
- "Antibiotics: MedlinePlus". nih.gov. Archived from the original on 27 July 2016. Retrieved 19 July 2016.
- "WHO's first global report on antibiotic resistance reveals serious, worldwide threat to public health". WHO. Archived from the original on 30 April 2014.
- Pugh R, Grant C, Cooke RP, Dempsey G (August 2015). "Short-course versus prolonged-course antibiotic therapy for hospital-acquired pneumonia in critically ill adults". The Cochrane Database of Systematic Reviews. 2015 (8): CD007577. doi:10.1002/14651858.CD007577.pub3. PMC 7025798. PMID 26301604.
- Giedraitienė A, Vitkauskienė A, Naginienė R, Pavilonis A (1 January 2011). "Antibiotic resistance mechanisms of clinically important bacteria". Medicina. 47 (3): 137–46. doi:10.3390/medicina47030019. PMID 21822035.
External links
| Library resources about Antibiotic |
- Antibiotic at Curlie
.jpg.webp)